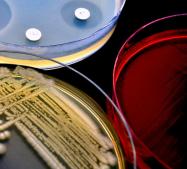

Immunotherapy that helps kids fight cancer without chemo. Automated cars that reduce accidents and hospitalizations. Virtual reality systems that help surgeons carry out procedures more safely. These are some of the medical innovations that could transform health care in 2017, according to the Cleveland Clinic, a large nonprofit hospital system.
Immunotherapy that helps kids fight cancer without chemo. Automated cars that reduce accidents and hospitalizations. Virtual reality systems that help surgeons carry out procedures more safely. These are some of the medical innovations that could transform health care in 2017, according to the Cleveland Clinic, a large nonprofit hospital system.
- Comment
- Reblog
-
Subscribe
Subscribed
Already have a WordPress.com account? Log in now.
Very interesting.
I wrote a post on blood sugar monitoring technology that might interest you
http://wp.me/p8vDkQ-6J